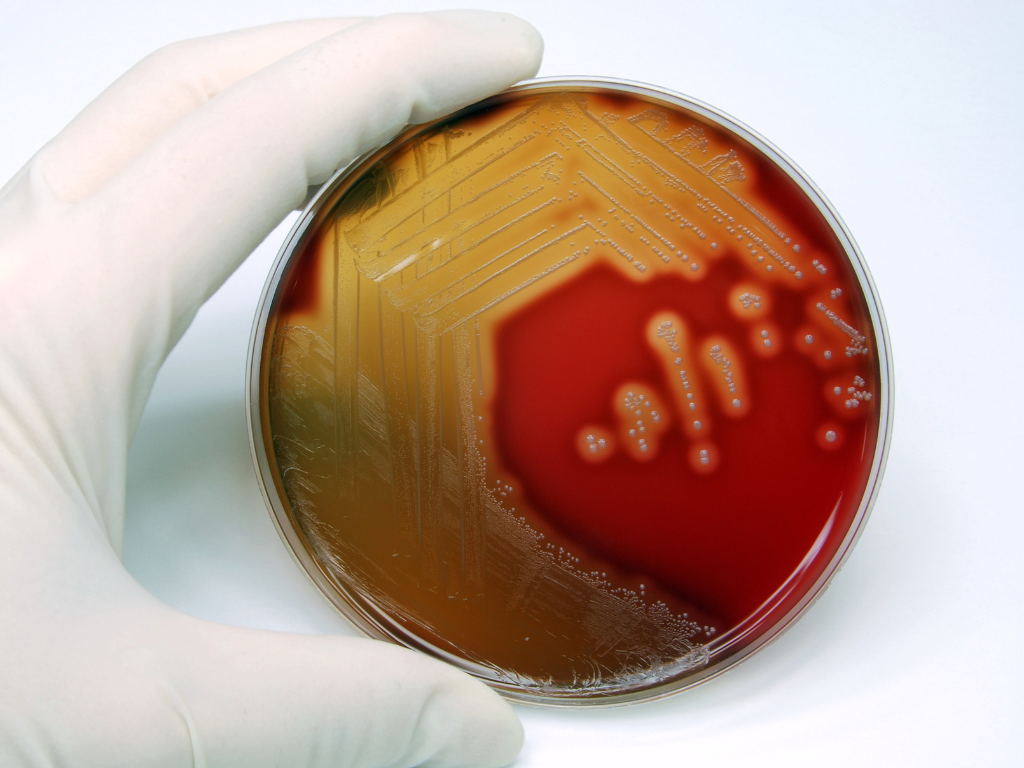

Meduplace helpt apothekers om nog meer in te zetten op farmaceutische dienstverlening rond geneesmiddelen. Hiervoor zoeken we partnerships met bedrijven en organisaties om te zoeken naar een win-win.

opvolgen van diabetespatiënten met poc-testing
Doel: nagaan in welke mate apothekers patiënten met diabetes type II kunnen begeleiden in de apotheek door POC-testing (HbA1c) in te zetten
Status: Tweede fase is lopende
Sponsor: Koninklijke Apothekersvereniging van Antwerpen (KAVA)
Partners: UAntwerpen, Roche
POC-testing: streptokokken
Doel: Nagaan in welke mate apothekers patiënten met streptokokkeninfectie kunnen identificeren en doorverwijzen naar de huisarts
Status: Afgelopen
Sponsor: Koninklijke Apothekersvereniging van Antwerpen (KAVA)
Partners: UAntwerpen
